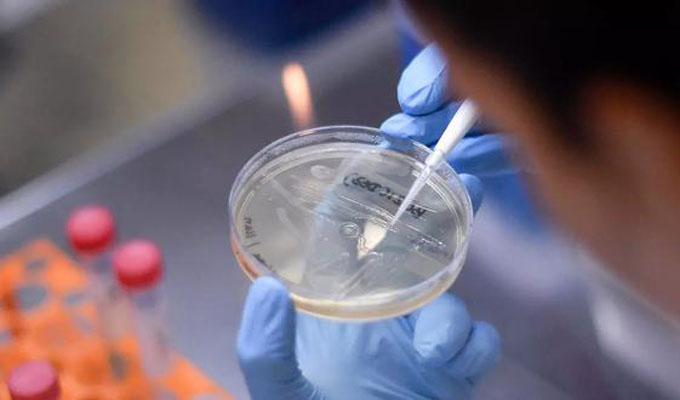

Covid-19: médicos piden calma ante caso sospechoso de la variante Delta en Sullana
Trascendió que se trataría de una mujer que hace 10 días se interno al confirmarse que tenía Covid-19, pero su salud de agravó y pasó a UCI.
Trascendió que se trataría de una mujer que hace 10 días se interno al confirmarse que tenía Covid-19, pero su salud de agravó y pasó a UCI.
En Piura, la Dirección Regional de Salud (Diresa) está en alerta ante un caso sospechoso de la variante Delta de la Covid-19 en Sullana, los médicos del Hospital de Apoyo II-2 indicaron que el caso no ha sido confirmado y que han tomado todas las precauciones.
Dante Ramírez Ríos, director de dicho nosocomio, dijo que se trataría de una mujer de 43 años, proveniente de Moquegua, que hace 10 días se interno al confirmarse que tenía Covid-19, pero su salud de agravó y pasó a la Unidad de Cuidados Intensivos (UCI).
“El hospital ha tomado inmediatamente las medidas de precaución y mantiene aislada a la paciente sospechosa de padecer de la variante Delta. Asimismo, la mujer está siendo monitoreada de cerca por especialistas que conocen cómo tratar estos casos”, expresó.
Dijo también que enviaron muestras al Instituto Nacional de Salud (INS) para determinar si se trata de la variante Delta, las cuales hasta el momento no han sido confirmadas por la referida institución, por lo que pidió calma, no alarmarse y esperar los resultados.
Panamericana Televisión S.A. Todos los Derechos Reservados 2017 • Aplicaciones móviles • Términos y Condiciones
Avenida Arequipa 1110 Santa Beatriz Lima 1 Perú • Central Telefónica: (+511)712-1000